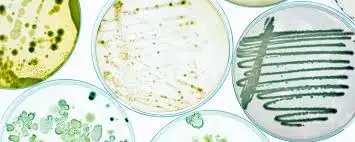
भारत सरकार ने उर्वरक नियमों का विस्तार कर नए बायोस्टिमुलेंट और माइक्रोबियल फॉर्मूलेशन को शामिल किया

֍:बायोस्टिमुलेंट के लिए नए मानक§ֆ:मुख्य परिवर्तनों में से एक में ह्यूमिक एसिड, फुल्विक एसिड और समुद्री शैवाल आधारित बायोस्टिमुलेंट के लिए विस्तृत विनिर्देशों को जोड़ना शामिल है, जो उनकी संरचना, अनुमेय सामग्री और विभिन्न फसलों के लिए अनुशंसित खुराक के लिए स्पष्ट दिशानिर्देश निर्धारित करते हैं। उदाहरण के लिए, ह्यूमिक एसिड 6% (तरल) में लियोनार्डाइट से प्राप्त कम से कम 6% पोटेशियम ह्यूमेट होना चाहिए, जबकि ह्यूमिक-फुल्विक एसिड 76% (पाउडर) में डेक्सट्रोज मोनोहाइड्रेट जैसे स्टेबलाइजर्स के साथ-साथ ह्यूमिक और फुल्विक एसिड का सख्त संतुलन बनाए रखना चाहिए। संशोधन में अनुप्रयोग विधियों की रूपरेखा भी दी गई है, जैसे टमाटर के लिए 1.25 लीटर प्रति हेक्टेयर और मिर्च के लिए 30 किलोग्राम प्रति हेक्टेयर मिट्टी में छिड़काव।§֍:समुद्री शैवाल और वनस्पति अर्क के लिए विनियम§ֆ:इसके अतिरिक्त, आदेश में समुद्री शैवाल अर्क के लिए मानक पेश किए गए हैं, जिसमें एस्कोफिलम नोडोसम और कप्पाफाइकस अल्वारेज़ी के फॉर्मूलेशन शामिल हैं, जो उनके एल्गिनिक एसिड सामग्री, कार्बनिक कार्बन स्तर और पीएच रेंज को निर्दिष्ट करते हैं। इन अर्क को ककड़ी, धान और बैंगन जैसी फसलों के लिए अनुशंसित किया जाता है, जिसमें पत्तियों और मिट्टी में उपयोग के लिए निर्धारित खुराक होती है। संशोधन में स्पिरुलिना और अधातोडा वासिका जैसे वनस्पति अर्क को भी शामिल किया गया है, जिसमें उनकी प्रोटीन सामग्री, घुलनशीलता और फसल-विशिष्ट उपयोग का विवरण दिया गया है।§֍:प्रोटीन हाइड्रोलिसेट्स और माइक्रोबियल फॉर्मूलेशन§ֆ:एक उल्लेखनीय समावेश प्रोटीन हाइड्रोलिसेट्स और अमीनो एसिड-आधारित उर्वरकों का विनियमन है, जो पौधे और पशु दोनों स्रोतों से प्राप्त होते हैं। इन फॉर्मूलेशन को मुक्त अमीनो एसिड सामग्री, कार्बनिक कार्बन स्तर और पीएच स्थिरता के लिए सख्त मानदंडों को पूरा करना चाहिए। उदाहरण के लिए, प्रोटीन हाइड्रोलिसेट 62.5% (पशु स्रोत) में कम से कम 21.6% मुक्त अमीनो एसिड होना चाहिए, जबकि अमीनो एसिड 10% (तरल) जैसे पौधे-आधारित वेरिएंट को विशिष्ट गुरुत्व और घुलनशीलता मानकों को बनाए रखना चाहिए। आदेश में खुराक संबंधी दिशा-निर्देश भी दिए गए हैं, जैसे कि हरे चने के लिए 1.25 लीटर प्रति हेक्टेयर और मिर्च के लिए 750 मिली प्रति हेक्टेयर।
संशोधन आगे चलकर जीवित माइक्रोबियल फॉर्मूलेशन में विस्तारित होता है, जिसमें मेथिलोकोकस कैप्सूलैटस और मेथिलोबैक्टीरियम प्रजातियों वाले उत्पादों के लिए व्यवहार्यता सीमाएँ निर्धारित की जाती हैं। उदाहरण के लिए, माइक्रोबियल संघ को प्रति स्ट्रेन 5 x 10^6 CFU/g की न्यूनतम व्यवहार्य गणना बनाए रखनी चाहिए, जिससे धान, मक्का और प्याज जैसी फसलों में प्रभावकारिता सुनिश्चित हो सके।
§֍:गुणवत्ता नियंत्रण और कार्यान्वयन§ֆ:गुणवत्ता नियंत्रण सुनिश्चित करने के लिए, आदेश माइक्रोबियल गणना के लिए सहनशीलता सीमा को परिभाषित करता है, जिसके तहत मिथाइलोकोकस कैप्सूलैटस को कम से कम 5 x 10^7 CFU/g और मिथाइलोबैक्टीरियम प्रजातियों के संघ को प्रति स्ट्रेन 2.5 x 10^6 CFU/g बनाए रखने की आवश्यकता होती है। इन उपायों का उद्देश्य रासायनिक उर्वरकों के लिए पर्यावरण के अनुकूल विकल्पों को बढ़ावा देते हुए बायोस्टिमुलेंट प्रभावकारिता को मानकीकृत करना है।
नए नियम आधिकारिक राजपत्र में प्रकाशन के बाद लागू होंगे, जो टिकाऊ कृषि की दिशा में एक महत्वपूर्ण कदम है। किसानों और निर्माताओं को अद्यतन आवश्यक वस्तु अधिनियम, 1955 के अनुपालन को सुनिश्चित करने के लिए इन दिशानिर्देशों का पालन करना चाहिए। इस कदम से फसल की पैदावार को बढ़ावा मिलने, पर्यावरणीय प्रभाव को कम करने और जैविक और सटीक खेती की ओर भारत के संक्रमण का समर्थन करने की उम्मीद है।
§कृषि एवं किसान कल्याण मंत्रालय ने उर्वरक (अकार्बनिक, जैविक या मिश्रित) (नियंत्रण) आदेश, 1985 में एक महत्वपूर्ण संशोधन पेश किया है, जिसका उद्देश्य फसल उत्पादकता को बढ़ाना और टिकाऊ खेती प्रथाओं को प्रोत्साहित करना है। उर्वरक (अकार्बनिक, जैविक या मिश्रित) (नियंत्रण) चौथा संशोधन आदेश, 2025 नामक नए आदेश में बायोस्टिमुलेंट, माइक्रोबियल फॉर्मूलेशन और जैव रासायनिक उर्वरकों के लिए व्यापक नियम पेश किए गए हैं।